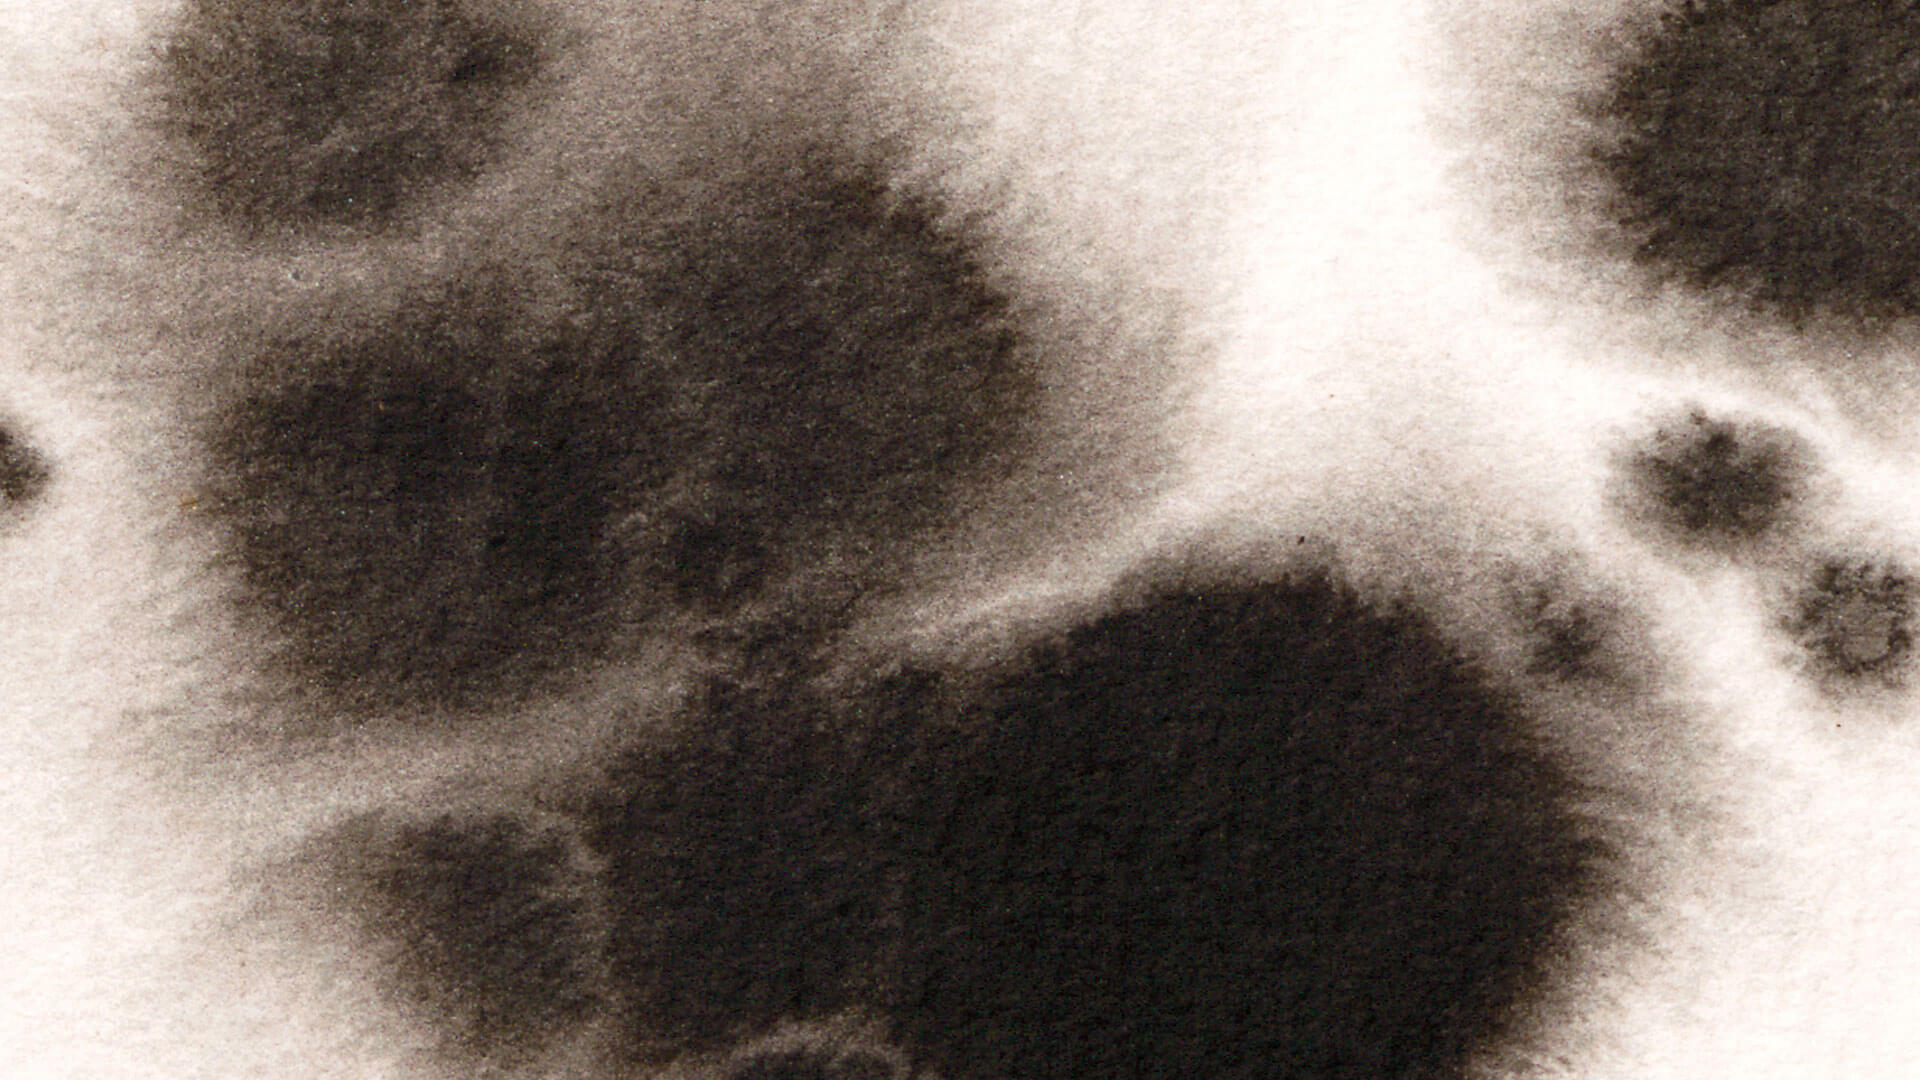

«Якщо темрява є відсутністю світла, то відсутність любові — це завжди пустота. І немає нічого страшнішого за цю пустоту в серцях, як немає тіні густішої за ту, що ховається в потаємних куточках людської душі».
«Книга Еміля» — роман Ілларіона Павлюка, для якого ми розробили суперобкладинку, айдентику світу книги і сам логотип письменника.
Суперобладинка
Айдентика книги
Лого
Сайт

Суперобкладинка стала частиною лімітованого видання книги та водночас — мапою прихованих сенсів роману.
Щоб не загубитися між світами і не збитися зі шляху, з’являється мапа у вигляді шкільної контурної карти. Еміль ще вчиться, і історія починається саме у школі. На карті є координати, за якими можна знайти підказки — ключові образи та символи роману, що робить її інтерактивною.



Головною особливістю проєкту стала графіка у вигляді плям. Вони схожі не лише на тест Роршаха, а й на саму депресію — головного антагоніста, з яким зіштовхується Еміль. Це рішення випливає з книги. Плями багатозначні: їх можна зчитувати як образи або як підказки для пошуку.













Фраза Ілларіона Павлюка: «Усе в цьому світі або заради любові, або через любов, або не має значення» — втілилася в логотипі у вигляді реалістичного серця. Усі його романи написані з особистого досвіду, тому кожен елемент, що проходить крізь нього, стає символом окремого твору.





2KA
Creative direction: Vika Moskofidi, Danya Nesterevych
Design: Vika Moskofidi, Danya Nesterevych, Sima Shpin
Autor: Illarion Pavliuk
Head of marketing: Anastasia Sokolova
Literary agent: Oksana Ziobro
Book cover: Agrafka Art Studio
Printed and published by Vydavnytstvo Staroho Leva
Website by digital design studio: Otse
Team: Dmytro Kozynets, Kateryna Yesipova,
Liza Sipko, Anastasia Butko, Andriy Frolov
3D: Sergii Irkhin
